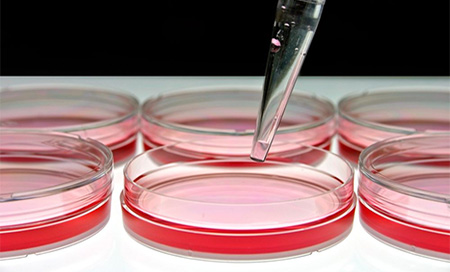
Descubren la proteína responsable de la regeneración del hígado

Tecnología
Descubren la proteína responsable de la regeneración del hígado
El estudio buscará solución a la cirroris y las formas de cáncer que pueden afectarlo
Ciertas células del hígado que contienen altos niveles de telomerasa regeneran este órgano, según un estudio realizado por investigadores de la Facultad de Medicina de la Universidad de Stanford, informa EurekAlert!.
La telomerasa es una proteína a menudo asociada con la resistencia al envejecimiento, y ahora un equipo de investigadores de Satnford ha logrado demostrar, en experimentos con ratones, que esta enzima cumple un rol de regeneración del hígado durante el recambio celular normal o daño tisular.
Descifrar esta notable capacidad de reparación y regeneración del hígado es un paso clave para comprender qué sucede cuando el órgano deja de funcionar correctamente, como en los casos de cirrosis o cáncer de hígado.
“Es fundamental entender el mecanismo celular que hace que el hígado se regenere. Hemos descubierto que estas células, raras y proliferativas, se diseminan por todo el órgano y que son necesarias para permitir que este reemplace las células dañadas. También es probable que puedan sustituirlas frente a cánceres de hígado cuando su regulación falla”, expresó el profesor de medicina Steven Artandi, autor principal del estudio publicado este 4 de abril en Nature.
